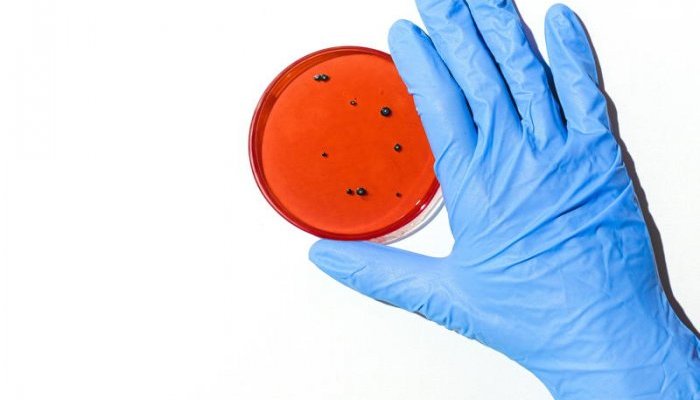

The new "Preclinical Testing" platform enables users to identify and select the most relevant testing methods depending on several criteria:
![]() Test category: Analytical tests, Content-contenair interaction, Ecotoxicity and Biodegradability tests, Safety tests, UV tests, efficacy tests...
Test category: Analytical tests, Content-contenair interaction, Ecotoxicity and Biodegradability tests, Safety tests, UV tests, efficacy tests...
![]() Claim: anti-ageing, anti-pollution...
Claim: anti-ageing, anti-pollution...
![]() Test support: cell cultures, 3D skin models... the various tests corresponding to his objectivation project and directly contact each test provider. A keyword search also simplifies the search.
Test support: cell cultures, 3D skin models... the various tests corresponding to his objectivation project and directly contact each test provider. A keyword search also simplifies the search.
Like the clinical tests platform, the new tool is accessible free of charge and without business commission.
A 360° panorama of the preclinical expertise
“It has been never been easier to identify the tests needed for your projects, thanks to the links Skinobs has made between methods and product claims, mechanisms of action and test solutions,” says Anne Charpentier, Skinobs’ founder.
In particular, the platform offers a detailed vision on efficacy tests. Cosmeticians can thus find the laboratory that meets their test criteria based on:
![]() Mechanisms of action: Acne, Adipocytes, Anti-Aging, Bioavailability, Skin Renewal, Free Radicals and Oxidation, Hydration, Inflammation, Biomechanical Integrity, Microbiota, Pigmentation, Pollution, Barrier Function, Regeneration...
Mechanisms of action: Acne, Adipocytes, Anti-Aging, Bioavailability, Skin Renewal, Free Radicals and Oxidation, Hydration, Inflammation, Biomechanical Integrity, Microbiota, Pigmentation, Pollution, Barrier Function, Regeneration...
![]() Analysis of 80 biomarkers: cytokeratin, collagen, Metallopeptidases-proteases, interleukins, hyaluronic acid, integrins, Interleukins...
Analysis of 80 biomarkers: cytokeratin, collagen, Metallopeptidases-proteases, interleukins, hyaluronic acid, integrins, Interleukins...
![]() Quantitative and/or visual analysis methods: gene expression, histology (morphology and imaging), protein and metabolic analysis...
Quantitative and/or visual analysis methods: gene expression, histology (morphology and imaging), protein and metabolic analysis...
![]() Choice of three levels of custom testing: custom protocol, 100% R&D studies and non-targeted "omics" tests.
Choice of three levels of custom testing: custom protocol, 100% R&D studies and non-targeted "omics" tests.
A comprehensive and independent platform
This extension strengthens the central position of the Skinobs platform within the cosmetics industry. It completes the clinical testing platform, which allows cosmeticians to identify relevant methods to support their claims for their active ingredients, finished products or medical devices including: tolerance tests, consumer tests, sensory analyses, efficacy tests on skin, hair or nails.
In 2019, 1,700 users from 58 countries have consulted it, viewing more than 19,000 pages.
“The success of this unique tool has been built on a collaborative relationship with industry players offering a global view of testing to cosmeticians with more than 300 methods and more than 90 laboratories referenced worldwide,” adds Anne Charpentier.
To become comprehensive, the referencing of CROs is continuous to bring together, gradually, all the global partners specialised in the preclinical evaluation of active and finished products on the skin, sebaceous glands and hair.
“Our aim is to offer a comprehensive and independent tool, and we know the adventure is just beginning,” concludes Charpentier.